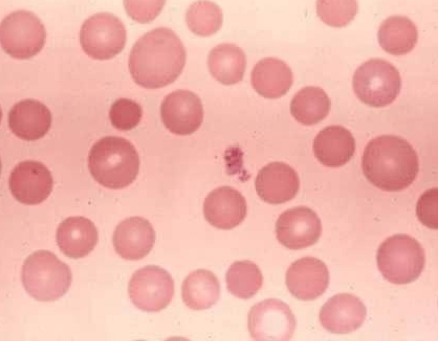

Sign up for FlowVella
Sign up with FacebookAlready have an account? Sign in now
By registering you are agreeing to our
Terms of Service
Loading Flow


Anisocytosis
The most common description would be the abnormality that they vary in size.
Common diseases/conditions are iron defiency, sideroblastic anemia, and vitaminA defiency.